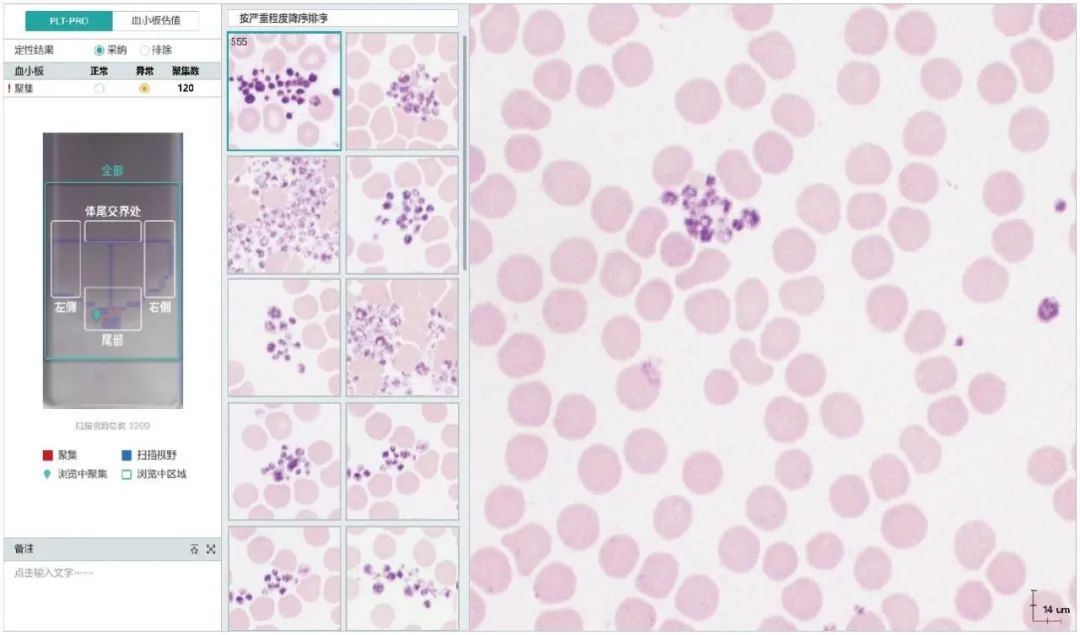

来源:迈瑞医疗
“阅片机好清楚啊,跟镜下状态非常接近!”
“这些样本这么快就检完了?”
“细胞的分类感觉和我自己区分相差不大!”
是什么让各大医院的检验科医生不约而同地发出这样的感叹?
很长一段时间里,许多医院检验科缺少镜检专业条件,面临着人手紧张,看片时间长,对细胞分类不尽准确等一系列问题,难以达到国内外专业机构提出的整体复检率近30%的目标。
洞察这一困扰后,迈瑞自2014年起走访全球数百家医院,与专家学者沟通,完成了“相机升级”、“结构调整”、“定制镜头”等多重环节的深度研发与创新。
今日,迈瑞全自动细胞形态学分析仪MC-80应运而生,邀您一起走进智慧阅片新时代,共同发现细胞真相。

细胞是生命活动的基本单位,细胞形态学检查是协助诊断血液系统疾病的基本手段之一。
观测细胞时,我们不仅仅需要获知特定细胞的数量分布,更要清晰地还原细胞立体的结构、细节,那一张张细胞的平面成像该如何实现这一点?

MC-80能够为每一个细胞在不同景深捕捉20张图像。
多景深融合技术的精髓在于能够模拟医生手动调焦,并在最终将20张图像中最为清晰的部分叠加在一起,助力检验科医生一目了然地洞悉细胞病理特征。


拍摄一大忌是“手抖”,背后的原理是——在光照恒定的情况下,图像愈追求清晰,曝光时间越长,对于降低拍摄抖动的要求就越高。求快还是求清晰,仿佛成为了一个单选题。
阅片领域亦如此,阻碍洞悉疾病真相的难题,除了清晰度,还有效率——唯有在更短时间内完成检测,方可提升镜检的普及率,提速成为了追求真相的关键之一。

MC-80匀高速拍摄不停歇,0.1s就能拍摄20张图片,一小时完成60个样本检测。同时,灵活的单片进样更能够保障紧急情况下结果的迅速生成。

经过反复验证,MC-80既能以新型航天材料的应用,保证仪器在高速运动时所需要的刚度;又能通过结构的稳定与先进的高频曝光算法,解决水平与垂直方向上的微弱抖动问题。
细胞形态学检测不仅仅需要发现细胞个体的真相,在血小板检测过程中,针对异常样本的“全方位照顾”也变得尤为重要。
要避免血小板聚集造成的假性降低,需兼顾常规细胞35倍以上的视野面积。这项工作在以往需要耗时费力的人工确认,今天迎来了变化。
MC-80独创的飞行扫描技术,能在一分钟内高速扫描涂片体部,两侧边缘和尾部,精准识别血小板聚集。

通过拟合全血膜对焦面,告别逐一对焦的漫长过程,辅以GPU实时大数据处理,MC-80在解放人力的同时保障了检测的全面与精准。
繁乱庞杂的信息海洋中,无序的信息不仅无效,更会成为获取真相的阻碍。
因此,完成对细胞图像的采集并不算结束,还需要正确分类,才能避免医生在浩如烟海的信息中陷入对不同细胞的反复挑选。现实情况却是——各类细胞特征相似度高,只有通过细节才能判断与区分。
MC-80通过对不同类细胞进行精准识别、预分类,能够较为准确地反映样本的全景情况,进一步呈现出病患的真实情况。

精准识别的背后,是对细胞数字图像特征的准确提取。基于前期形态学、病理学专家给出的指导特征,MC-80能够在不同尺度下提取出每个细胞的色彩、纹理和几何特征信息,结合细胞大类与小类比对,最终精准锁定细胞分类。
不仅如此,MC-80更享有智能化阅片规则,能够在阅片前、阅片中根据实际情况调整阅片模式,将异常信息进行智慧分类,大大提升了阅片效率。

如遇技术难题,MC-80更支持多终端远程审核,让多方会诊无需片刻即可触达。


以硬核技术驱散检验迷雾
以高效精准还原细胞真相
迈瑞全自动细胞形态学分析仪
今日正式发布



个人中心
我是园区